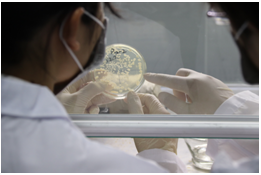

聯系人:林經理
電 話:15013809846
微 信:15013809846
傳 真:0755-89641863
Q Q :2250469268
地 址:深圳市龍崗區坪地街道高橋社區教育北路82號
倉庫分銷地址:
深圳市寶安區松崗街道碧頭第一工業區78號
汕頭市潮南區峽山鎮洋內村廣洋路
江門市江海區禮樂鎮武東村委旁大鵬超市
惠州市惠城區小金口辦事處祥達路19號
中山市民眾鎮浪網村
佛山市高明區楊和鎮獨崗村和滿路8號
江蘇省徐州市泉山區泉山開發區騰飛路
河南省鄭州市新鄭市孟莊鎮南常口村
浙江省紹興市越城區蕺山街道樂苑新村桃園
淄博市淄川區鐘樓街道東譚村東譚社區
福建省泉州市晉江市內坑鎮上方村
工廠分銷地址:
江蘇省南京市六合區大緯東路
河南省焦作市中站區新園工業園
湖北省襄陽市南漳縣城關鎮久龍大道
江蘇省淮安市淮安區馬甸鎮馬甸工業園區
廣東省云浮市云安區六都鎮
山東省淄博市博山區秋谷橫里河路55號
山東省煙臺市龍口市開發經濟區和平路
山東省濟南市天橋區新材料工業園裕新路
廣西壯族自治區梧州市藤縣化工工業區
廣西柳州市鹿寨縣鹿寨鎮建中西路100號
廣西壯族自治區百色市右江區龍景街道
四川省德陽市綿竹市新市工業園區
宜春市萬載縣工業園區創業大道9號
